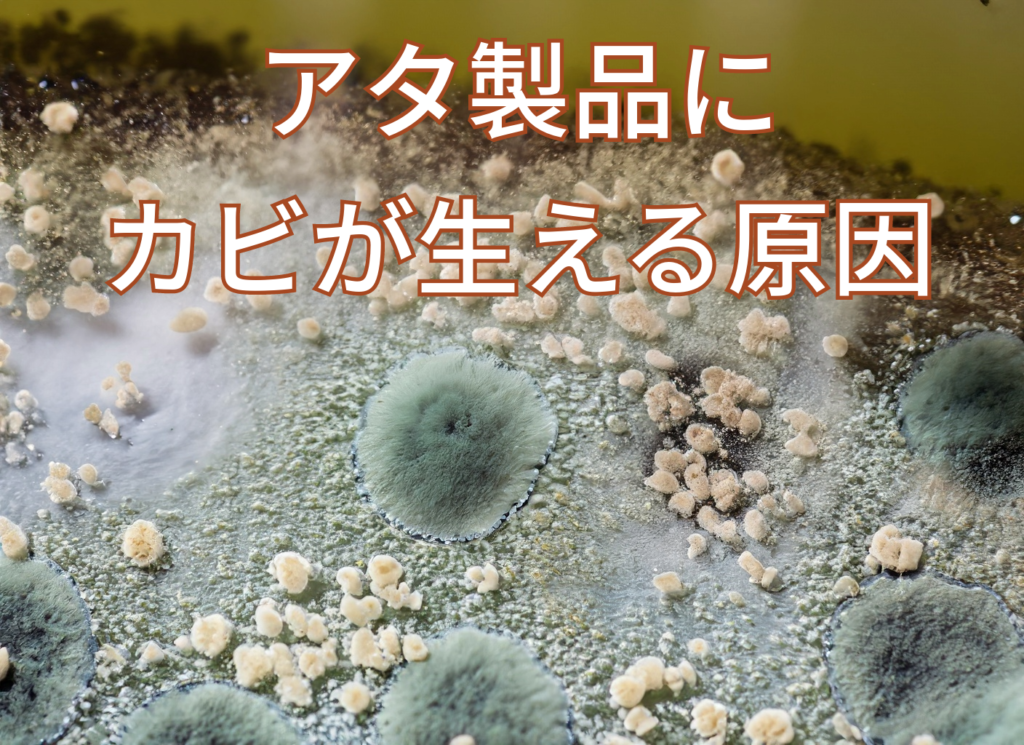

アタ製品とは何か?:素材から製法までの基本知識
アタ製品の素材と特性
みなさん、アタ製品ってご存知ですか?アタとは、実は南東アジアのトウヒョウヤシから取れる繊維なんです。このアタ繊維は、非常に強くて耐久性があるのが特徴なんですよ。バッグやカゴ、さまざまなインテリアに使われています。アタ製品は見た目もナチュラルで美しいので、エコなライフスタイルにぴったりです。専門的には、アタ繊維の強靭さと形状の安定性が、その人気の秘密なんです。
アタ製品の製造工程
アタ製品の製造工程、これがまた面白いんですよ。まずアタの葉を収穫し、太陽の下で自然乾燥させます。その後、葉から繊維を取り出し、職人さんが一本一本丁寧に編んでいくんです。この手作業が、アタ製品の温かみと個性を生み出しているんですね。そして、製品によっては、天然染料で色付けされることも。工程を知ると、一つ一つの製品がいっそう特別に感じられると思いませんか?
世界中でのアタ製品の使用
アタ製品は、インドネシアやフィリピンなどの国々で古くから愛されているんです。特にバリ島では、伝統的なカゴやバッグとしてよく使われていますよ。近年では、世界中でエコブームと共に人気が高まっているんです。デザイン性と機能性が両立しているので、ファッションアイテムやインテリアとしてもおすすめ。おしゃれなアタ製品、ぜひお部屋やコーディネートに取り入れてみてはいかがでしょうか?自然素材の温かみと、エコな価値観がきっと新しい魅力をもたらしてくれるはずです。
アタ製品にカビが生える原因:湿度と保存方法の影響
湿度と温度の影響
湿度と温度、これらの要素がカビの成長にどう影響するか、ちょっとお話ししましょう。アタ製品は自然素材でできているので、湿度が高い場所ではカビが発生しやすいんです。暑く湿った季節、特に夏場は要注意ですね。湿度が60%以上になると、カビが生えやすくなるのが一般的。空調や除湿器で室内の湿度をコントロールすることが、カビ予防につながるんですよ。温度も関係ありますが、湿度がキーポイントとなることが多いので、お部屋の湿度をチェックする習慣をつけると良いかもしれませんね。
不適切な保存方法のリスク
アタ製品のカビ、実は保存方法にも関係しているんです。例えば、バッグやカゴを閉めきったクローゼットにしまうと、通気性が悪くなってカビの温床に。専門的に言うと、通気性が悪い場所は湿度が上がりやすく、カビが発生しやすい環境なんです。保存する際は、通気性の良い場所を選ぶか、定期的に風通しをすることが大切。アタ製品を長く美しく使いたいですよね、だからこそ、正しい保存方法に少し気を付けてみてください。
季節と地域性の要因
季節と地域によっても、アタ製品のカビの発生状況が変わること、ご存知でしたか?湿度が高い地域や梅雨時期などは特に注意が必要なんです。例えば、海辺の地域や雨が多い場所では、カビの予防対策をしっかりと行う必要があるでしょう。季節でいうと、夏から秋にかけてのジメジメした時期もリスクが高いですね。地域性や季節を考慮して、それぞれの状況に合った保管やお手入れをすると、アタ製品を長く愛用できるはず。お住まいの地域の特性を把握して、カビ対策に活かしましょう!
カビの予防策:アタ製品を長持ちさせるためのガイドライン
適切な保存場所の選定
さあ、アタ製品のカビ予防策、第一歩は保存場所の選び方から始めましょう。素材がデリケートなので、湿度が高い場所や直射日光は避けたいところ。実は、湿度を一定に保つための通気性が重要なんですよ。直射日光も色褪せや乾燥を引き起こす原因に。だから、風通しの良い場所に、適度な日陰で保管するのがベスト。こうした配慮は、アタ製品の美しさを長く保つ秘訣ですね。
定期的なメンテナンスと清掃
アタ製品を長持ちさせるためには、定期的なメンテナンスと清掃が欠かせません。普段使っていると気づかない汚れや湿気がたまることもあるので、月に一度は丁寧に拭き掃除を。専門的に言うと、柔らかい布と中性洗剤がおすすめですね。そして乾かす際は、風通しの良い陰干しで。あまり難しく考えず、普段の掃除の一環として取り入れるだけで、アタ製品がずっと新しいままでいられるんです。
予防を目的とした専用製品の使用
カビ予防のための専用製品、これも一考の価値ありですよ。市販されている除湿剤や、自然素材用の防カビスプレーなどが便利。選ぶ際は、アタ製品に優しい成分が含まれているものをチェックしましょう。専門店では、アタ製品専用のケア用品も見かけますね。こうした商品を使うことで、カビの発生を最小限に抑えることが可能。お気に入りのアタ製品を長く大切に使いたいなら、これらの予防製品の活用もおすすめです。
カビが発生した際の初期対応:素早い手順でのクリーニング方法
カビの早期発見の重要性
まず最初に覚えておきたいのは、カビの早期発見がとても重要だということ。カビがアタ製品に着いたまま長い時間放置すると、色が変わったり素材が弱くなったりしますからね。時々アタ製品をチェックして、少しでもカビを見つけたらすぐに対処しましょう。特に湿度の高い季節には注意が必要です。早期発見が、後々のお手入れを格段に楽にする秘訣なんですよ。
手元でできるクリーニング方法
カビを見つけたら、まずは手元でできるクリーニング方法から始めましょう。専門用語で言うなら、ソフトブラシで表面を優しくこすり、中性洗剤で拭き取るという方法が基本。濡れたままにせず、風通しの良い場所できちんと乾かしましょうね。ちなみに、カビの種類によっては一度で落ちないこともあるから、何度か繰り返すことが大切。手元でのクリーニングは簡単なものですが、カビが広がるのを防ぐ第一歩なんです。
カビ対策専門家への相談
それでもカビが取れない場合、専門家への相談も選択肢の一つですよ。アタ製品の専門店やクリーニング店なら、カビの種類や広がりに合わせた対策を提案してくれることでしょう。専門的な言葉で言うならば、深い部分まで浸透したカビを除去するための特殊な方法があるんです。自分での処理が難しい場合、適切な処理を求めるためにも、プロに任せるのが最善の選択かもしれませんね。
カビの対策は、早めの発見と適切な対処が大切。自分でできる範囲でクリーニングし、必要なら専門家への相談も忘れずに。そうすれば、お気に入りのアタ製品も、ずっと美しい状態で使い続けられるでしょう。少しの注意で、大切なアイテムを長く愛用できるように、一緒にがんばりましょうね!
アタ製品のプロフェッショナルクリーニング:専門店の利用と効果
専門店でのクリーニングプロセス
専門店でのクリーニング、ちょっとワクワクしますよね。アタ製品に合った、専門的な手法でお手入れしてくれるんですよ。まずは、カビの状態や素材をしっかりチェック。そして、適切な洗剤や工程で丁寧にクリーニング。最後に、乾燥機ではなく自然乾燥で仕上げるところがポイントです。専門店だからこその手順で、アタ製品を本来の美しさに戻してくれるんです。
コストと期間の評価
お値段と期間、気になるところですよね。アタ製品の専門クリーニングは、一般的なクリーニングよりも少し高めのことが多いです。でも、その分、技術と経験があるプロの手によるケアが受けられるんですよ。期間に関しては、カビの状態や混み具合によって変わることも。少し時間はかかるかもしれませんが、お気に入りのアタ製品を元の美しさに戻す価値は十分あると思います。
専門店の選び方
専門店選び、これが意外と難しいんですよね。まずは、店舗の評判をチェックすることから始めましょう。口コミサイトやSNSでの評価などが参考になります。次に、店舗に直接問い合わせてみて、アタ製品のクリーニング経験や取り扱い方法を確認するのもいいでしょう。そして、もちろん、費用や期間についてもしっかり確認。自分のニーズに合った専門店を選ぶことで、アタ製品の長寿命化につながるんです。
専門店でのクリーニングは、アタ製品の美しさを取り戻す最良の方法かもしれませんね。少し高くても、大切なアイテムに対する愛情を感じる、そんなクリーニング体験。ぜひ、自分に合った専門店を見つけて、お気に入りのアタ製品を長く愛用してみてください。プロの技が光るクリーニングで、アタ製品が新品同様に蘇る感動を、一度は味わってみてほしいですね。
カビの健康への影響:アタ製品と共通する生活用品でのリスク管理
専門店でのクリーニングプロセス
専門店でのクリーニング、ちょっとワクワクしますよね。アタ製品に合った、専門的な手法でお手入れしてくれるんですよ。まずは、カビの状態や素材をしっかりチェック。そして、適切な洗剤や工程で丁寧にクリーニング。最後に、乾燥機ではなく自然乾燥で仕上げるところがポイントです。専門店だからこその手順で、アタ製品を本来の美しさに戻してくれるんです。
コストと期間の評価
お値段と期間、気になるところですよね。アタ製品の専門クリーニングは、一般的なクリーニングよりも少し高めのことが多いです。でも、その分、技術と経験があるプロの手によるケアが受けられるんですよ。期間に関しては、カビの状態や混み具合によって変わることも。少し時間はかかるかもしれませんが、お気に入りのアタ製品を元の美しさに戻す価値は十分あると思います。
専門店の選び方
専門店選び、これが意外と難しいんですよね。まずは、店舗の評判をチェックすることから始めましょう。口コミサイトやSNSでの評価などが参考になります。次に、店舗に直接問い合わせてみて、アタ製品のクリーニング経験や取り扱い方法を確認するのもいいでしょう。そして、もちろん、費用や期間についてもしっかり確認。自分のニーズに合った専門店を選ぶことで、アタ製品の長寿命化につながるんです。
専門店でのクリーニングは、アタ製品の美しさを取り戻す最良の方法かもしれませんね。少し高くても、大切なアイテムに対する愛情を感じる、そんなクリーニング体験。ぜひ、自分に合った専門店を見つけて、お気に入りのアタ製品を長く愛用してみてください。プロの技が光るクリーニングで、アタ製品が新品同様に蘇る感動を、一度は味わってみてほしいですね。
ケーススタディ:カビによるアタ製品のダメージと修復の実例
ダメージの程度と修復の可能性
カビによるダメージ、これってどれくらい修復できるものなのでしょうか。実は、ダメージの程度によって修復の可能性は変わってくるんですよ。軽度ならば、自宅でのお手入れでも綺麗にすることができることも。でも、重度のダメージの場合、専門のお店に依頼するのがベストです。カビによる色落ちや形の崩れなど、専門的な知識が必要な場合もあるんですね。ダメージをしっかりと診断してから、修復の方針を決めると良いかもしれません。
修復の前後での製品の変化
さて、カビからアタ製品を取り戻したいと思ったら、どれくらいの変化が見られるのでしょうか。軽度のダメージなら、カビの色が消え、製品の美しさが戻ることが多いです。重度の場合も、専門店の手にかかれば、新品同様に戻ることもあるんですよ。ただし、素材によっては修復後も少し変色が残ることも。それもまた、一つの風合いとして楽しむのも素敵かもしれませんね。
実際の修復事例の紹介
今回は、私の友人がカビで悩んでいたアタ製のバッグの修復事例をご紹介します。このバッグ、彼女のお気に入りで、湿気の多い場所に置いてしまいカビが発生。最初はショックだったそうですが、専門店でのクリーニングを決意。結果は大成功!バッグはほぼ元通りの美しさを取り戻しました。コストも思っていたよりも手頃で、彼女は大満足。カビに負けず、大切なアイテムを長く楽しむための一例として、参考になれば嬉しいです。
カビのダメージ、最初はとても落ち込みますが、適切な対処で愛用のアイテムを取り戻せることも多いんですよ。専門家に相談する勇気と、適切なケアで、大切なアタ製品との長い付き合いを楽しんでみませんか。私たちの生活に馴染むアタ製品、その美しさと特別な思い出を大切にしましょう。
カビ対策製品の比較:市販されているクリーニング剤のレビュー
一般的なクリーニング剤の特徴
アタ製品のカビ取りに使える一般的なクリーニング剤、みなさんもよく見かけることがあるかもしれませんね。これらの製品は、手軽に使えて、お値段もお手頃なところが魅力です。例えば、スーパーで売られているものなど、カビ取りのための化学成分を配合して効果を発揮することが多いですよ。でも、強い成分が入っていることもあるので、素材によっては使えないことも。ラベルの使用方法や注意事項をしっかり読んで、適切に使用することが大切ですね。
専門的なカビ取り剤の評価
次に、カビ対策に特化した専門的なカビ取り剤です。これらの製品は、カビの種類や発生状況に合わせて効果を発揮する成分が調合されています。プロも使用するような商品もあって、その効果は高いものが多いんですよ。アタ製品に特化したものもあるので、選び方次第でピッタリの製品が見つかるかもしれません。ただ、専門的な製品だけに価格は少し高めかもしれませんね。
自然素材を使用したエコ製品の選択
さて、自然派の方におすすめなのが、自然素材を使用したエコ製品です。人や環境に優しい成分で作られているため、肌に触れることが多いアタ製品に使うのに安心感がありますよね。例えば、お酢や重曹を使ったカビ取り剤など、家庭でも作れるレシピもありますよ。もちろん市販のエコ製品もたくさん。エコに関心のある方にとっては、こちらの選択も魅力的です。
カビ対策製品選びは、自分のライフスタイルやアタ製品の特性、気になるカビの状況に合わせて選ぶと良いでしょう。手軽なものから、専門的なもの、自然派のものまで、幅広い選択肢がありますから、自分に合った最良の製品を見つけて、大切なアタ製品を守りましょう。選び方や使い方に迷ったら、専門店に相談するのも一つの方法ですよ。
アタ製品のカビをテーマにしたコミュニティと専門家の意見
オンラインコミュニティとフォーラム
アタ製品のカビ対策について、オンラインで情報交換できる場所がありますよ。SNSや専門フォーラムなど、同じ悩みを持つ方々が集まってアドバイスを共有したりするんです。私も時々覗いてみるんですが、意外なテクニックや製品のレビューなど、とても役立つ情報がいっぱいですよ。ただ、情報の正確性には気をつけなくちゃいけませんから、試す前にはしっかりと信頼性をチェックすることが大切ですね。
カビ対策の専門家とのインタビュー
カビ対策の専門家の方々に直接お話を聞くのも、とても有益ですよ。実際に私が何人かの専門家にインタビューした結果、アタ製品のカビ対策についての深い知識と科学的な根拠に基づいた助言が得られました。専門家の意見は、時に私たちの常識を覆すことも。最新のカビ対策技術や新しい製品の評価など、確かな情報が手に入りますよ。専門書やセミナー、オンラインの記事などで、専門家の意見をチェックしてみるのもいいですね。
アタ製品のカビ対策は、一人で悩まずに、さまざまな人々とのコミュニケーションを通じて解決する道もあるんです。お困りの方は、ぜひこうしたコミュニティに参加してみて、新しい情報や支援を得てみてはいかがでしょうか。一人ひとりの経験が、みんなの役に立つこともあるんですよ。
未来のアタ製品:カビに強い新素材と保存技術の展望
新素材と技術の開発動向
皆さん、最近のアタ製品の素材と技術の進化についてご存知ですか?カビに強い新素材の開発や保存技術の向上が進んでいるんですよ。例えば、ナノテクノロジーを利用したカビ防止コーティングなど、とても先進的です。もちろん、使い心地や見た目も、以前のアタ製品と変わらない美しさがあります。この新しい動向には、私もわくわくしています。未来のアタ製品は、現在の問題を解決するために、科学者や職人さんが手を取り合って進化しているんですね。
未来のアタ製品の市場展望
未来のアタ製品は、ただカビに強いだけではありません。デザインや機能性も進化し、ますます多様なニーズに応える商品が登場しているんですよ。新素材の採用により、耐久性が上がり、長く愛用できる商品が増えると予測されています。また、エコフレンドリーな素材の使用など、環境にも配慮した製品も増えてきています。市場は拡大しており、多くの人々がアタ製品の魅力に取りつかれている今日、この動向はとても期待できるものとなっています。
サステナビリティと環境への配慮
Ωサステナビリティと環境への配慮についてお話ししたいと思います。未来のアタ製品の開発では、地球に優しい素材の選定や製造プロセスの改善が進んでいるんです。たとえば、化学薬品を使わずにカビを防ぐ方法や、リサイクル可能な素材の使用など、環境に配慮した取り組みが盛んです。私たちが日常で使うアタ製品も、地球にやさしい未来を築く一翼を担う存在になりつつあるんですよ。だから、次にアタ製品を選ぶときは、このような取り組みにもぜひ注目してみてくださいね。
未来のアタ製品は、技術とデザイン、そして環境への思いやりが一体となって進化しています。私たち消費者も、この素晴らしい動きに気づき、支えていく役割があると感じます。新しいアタ製品を選ぶ楽しみが、これからもっと広がることでしょうね!


コメント